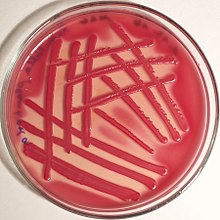

Raoultella
| Raoultella | |
|---|---|
 | |
| Raoultella planticola | |
| Scientific classification | |
| Domain: | |
| Phylum: | |
| Class: | |
| Order: | |
| Family: | |
| Genus: | Raoultella Drancourt et al., 2001 |
| Species | |
|
Raoultella electrica | |
The genus Raoultella is composed of Gram-negative, oxidase-negative, aerobic, nonmotile, capsulated, facultatively anaerobic rods (formerly designated Klebsiella) in the family Enterobacteriaceae. It is named after the French bacteriologist Didier Raoult.[1][2][3] The existence of this genus renders the genus Klebsiella paraphyletic, and it has been repeatedly proposed to consider Raoultella a junior synonym of Klebsiella.
Description
Members of genus Raoultella grow at 10 °C consistent with their recovery from plants, soil, and water, whereas members of Klebsiella do not grow at 10 °C[4] and are mainly recovered from mammals' mucosae. Klebsiella oxytoca is an exception, and a proposal to classify K. oxytoca in a separate, unnamed genus has been made.[5]
It consists of species Raoultella electrica, Raoultella ornithinolytica, Raoultella planticola and Raoultella terrigena.[6]
In human infections, Raoultella species are generally sensitive to treatment with carbapenems. In one series, 92% were sensitive to ciprofloxacin. More than 10% produced extended-spectrum beta-lactamases.[7]
Species
Type species for this genus are:
- Raoultella electrica 1GBT[8][9]
- Raoultella ornithinolytica ATCC 31898T[1][10]
- Raoultella planticola ATCC 33531T[1][11]
- Raoultella terrigena ATCC 33257T[1][12]
Synonym
A phylogenetic tree of Klebsiella, based on a 2.93-Mbp alignment, unambiguously places R. ornithinolytica sister to K. oxytoca within the larger Klebsiella phylogeny and suggests abandoning the genus Raoultella designation.[13]
Robust phylogenetic analyses have repeatedly shown that species classified into this genus are nested in the genus Klebsiella, indicating Raoultella should be abandoned and considered a junior synonym of Klebsiella.[14][15][16][17]
In November 2021, the synonym Klebsiella electrica is reported "not validly published".[18] The correct name with a valid nomenclatural status is Raoultella electrica.[9]
References
- 1 2 3 4 Drancourt, M; Bollet, C; Carta, A; Rousselier, P (May 2001). "Phylogenetic analyses of Klebsiella species delineate Klebsiella and Raoultella gen. nov., with description of Raoultella ornithinolytica comb. nov., Raoultella terrigena comb. nov. and Raoultella planticola comb. nov". International Journal of Systematic and Evolutionary Microbiology. 51 (Pt 3): 925–32. doi:10.1099/00207713-51-3-925. PMID 11411716.
- ↑ "Genus Raoultella". List of Prokaryotic names with Standing in Nomenclature. Archived from the original on 2021-10-12. Retrieved 2021-09-20..
- ↑ "Raoultella". Encyclopedia of Life. Archived from the original on 2021-02-09. Retrieved 2021-09-20..
- ↑ Manual of clinical microbiology. Patrick R. Murray, Ellen Jo Baron (9th ed.). Washington, D.C. 2007. p. 705. ISBN 978-1-55581-587-5. OCLC 647917473.
{{cite book}}: CS1 maint: location missing publisher (link) CS1 maint: others (link) - ↑ Jain, K.; Radsak, K.; Mannheim, W. (1974). "Differentiation of the Oxytocum group from Klebsiella by deoxyribonucleic acid hybridization". Int J Syst Bacteriol. 24 (4): 402–407. doi:10.1099/00207713-24-4-402.
- ↑ J.P. Euzéby: List of Prokaryotic names with Standing in Nomenclature – integrated into the DSMZ’s Prokaryotic Nomenclature Up-to-date (PNU) database
- ↑ Sêkowska, Alicja; Bogiel, Tomasz; Woźniak, Marcin; Gospodarek-Komkowska, Eugenia (2020-02-01). "Raoultella spp. – reliable identification, susceptibility to antimicrobials and antibiotic resistance mechanisms". Journal of Medical Microbiology. 69 (2): 233–238. doi:10.1099/jmm.0.001150. ISSN 0022-2615. PMID 31971501.
- ↑ Kimura, Z; Chung, KM; Itoh, H; Hiraishi, A; Okabe, S (April 2014). "Raoultella electrica sp. nov., isolated from anodic biofilms of a glucose-fed microbial fuel cell". International Journal of Systematic and Evolutionary Microbiology. 64 (Pt 4): 1384–8. doi:10.1099/ijs.0.058826-0. PMID 24449794.
- 1 2 "Species Raoultella electrica". List of Prokaryotic names with Standing in Nomenclature. Archived from the original on 2021-11-10. Retrieved 2021-10-12..
- ↑ "Species Raoultella ornithinolytica". List of Prokaryotic names with Standing in Nomenclature. Archived from the original on 2021-10-13. Retrieved 2021-10-13..
- ↑ "Species Raoultella planticola". List of Prokaryotic names with Standing in Nomenclature. Archived from the original on 2020-08-04. Retrieved 2021-10-12..
- ↑ "Species Raoultella terrigena". List of Prokaryotic names with Standing in Nomenclature. Archived from the original on 2021-10-19. Retrieved 2021-11-05..
- ↑ Hudson, Corey; Bent, Zachary; Meagher, Robert; Williams, Kelly (June 6, 2014). "Resistance Determinants and Mobile Genetic Elements of an NDM-1-Encoding Klebsiella pneumoniae Strain". PLOS ONE. 9 (6): e99209. Bibcode:2014PLoSO...999209H. doi:10.1371/journal.pone.0099209. PMC 4048246. PMID 24905728.
- ↑ Corey M Hudson; Zachary W. Bent; Robert J. Meagher; Kelly P. Williams (2014). "Resistance determinants and mobile genetic elements of an NDM-1-encoding Klebsiella pneumoniae strain". PLOS One. 9 (6): e99209. Bibcode:2014PLoSO...999209H. doi:10.1371/JOURNAL.PONE.0099209. ISSN 1932-6203. PMC 4048246. PMID 24905728. Wikidata Q21132017.
- ↑ Yuanyuan Ma; Xiuqin Wu; Shuying Li; Lie Tang; Mingyue Chen; Qianli An (June 2021). "Proposal for reunification of the genus Raoultella with the genus Klebsiella and reclassification of Raoultella electrica as Klebsiella electrica comb. nov". Research in Microbiology. 172 (6): 103851. doi:10.1016/J.RESMIC.2021.103851. ISSN 0923-2508. Wikidata Q108677989.
- ↑ Harry Thorpe; Ross Booton; Teemu Kallonen; et al. (5 August 2021). "One Health or Three? Transmission modelling of Klebsiella isolates reveals ecological barriers to transmission between humans, animals and the environment". bioRxiv. doi:10.1101/2021.08.05.455249. Wikidata Q108866689.
- ↑ Marjorie J Gibbon; Natacha Couto; Sophia David; et al. (8 January 2021). "A high prevalence of bla OXA-48 in Klebsiella (Raoultella) ornithinolytica and related species in hospital wastewater in South West England". Microbial genomics. 7 (3). doi:10.1099/MGEN.0.000509. ISSN 2057-5858. PMC 8190614. PMID 33416467. Wikidata Q104798151.
- ↑ "Species Klebsiella electrica". List of Prokaryotic names with Standing in Nomenclature. Archived from the original on 2021-11-10. Retrieved 2021-11-10.